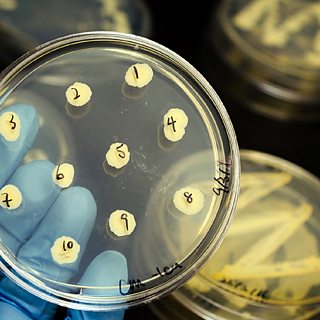

蜜芽传媒 Learning English - Take Away English: Man vs bacteria - 蜜芽传媒 Sounds

蜜芽传媒 Learning English - Take Away English: Man vs bacteria - 蜜芽传媒 Sounds
Take Away English: Man vs bacteria
Scientists are concerned about microbes' resistance
Scientists are concerned about microbes' resistance